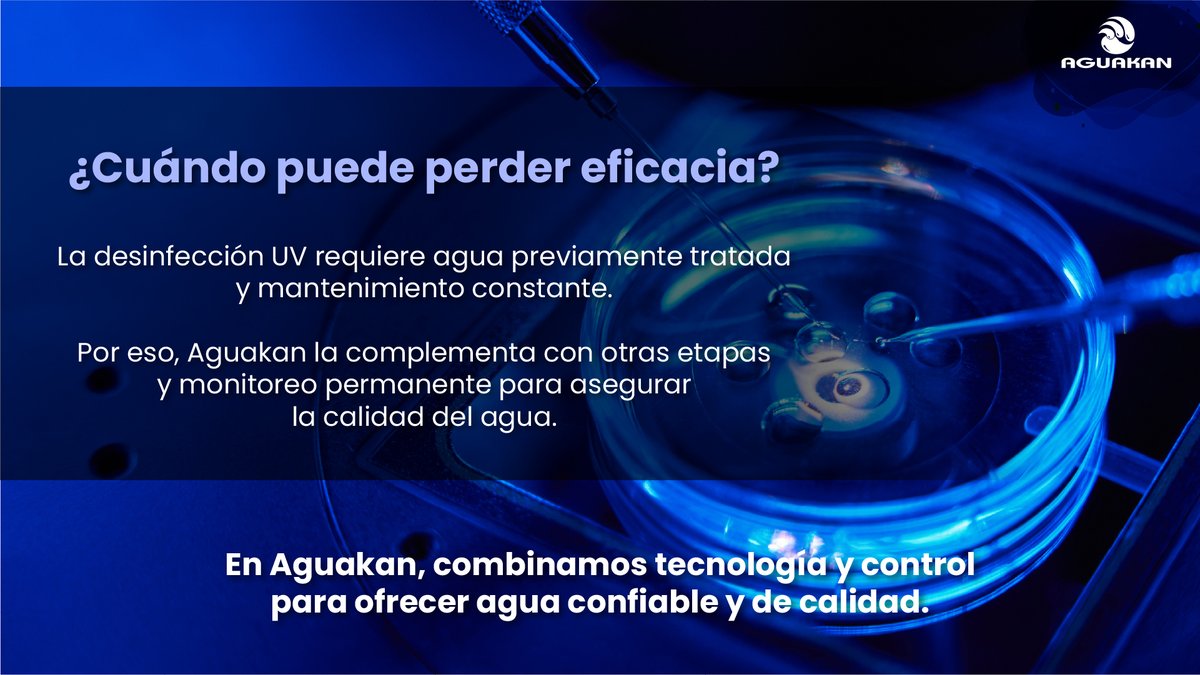
Aguakan tweet media

Dani Sureste
1.4K posts












Este video envejece como el vino. Con el paso de los años, el tiempo le da más razón a @FelipeCalderon. Lo advirtió y como si se tratase de una profecía: hoy tenemos un presidente que no enfrenta a los criminales, y su sexenio ya es el más sangriento de la historia de México.

@anapatyp @VigiaCiudadano7 Con todo respeto para esta personita ¿ Aquí no viene el Secretario del ayuntamiento ( PAUBLITO) A rescatar a un ser humano?




























El Artículo 2, párrafo 4 de la Carta de las Naciones Unidas dice textualmente: “Los Miembros de la Organización, en sus relaciones internacionales, se abstendrán de recurrir a la amenaza o al uso de la fuerza contra la integridad territorial o la independencia política de cualquier Estado, o en cualquier otra forma incompatible con los Propósitos de las Naciones Unidas.” La posición del gobierno de México: gob.mx/sre/prensa/mex…



